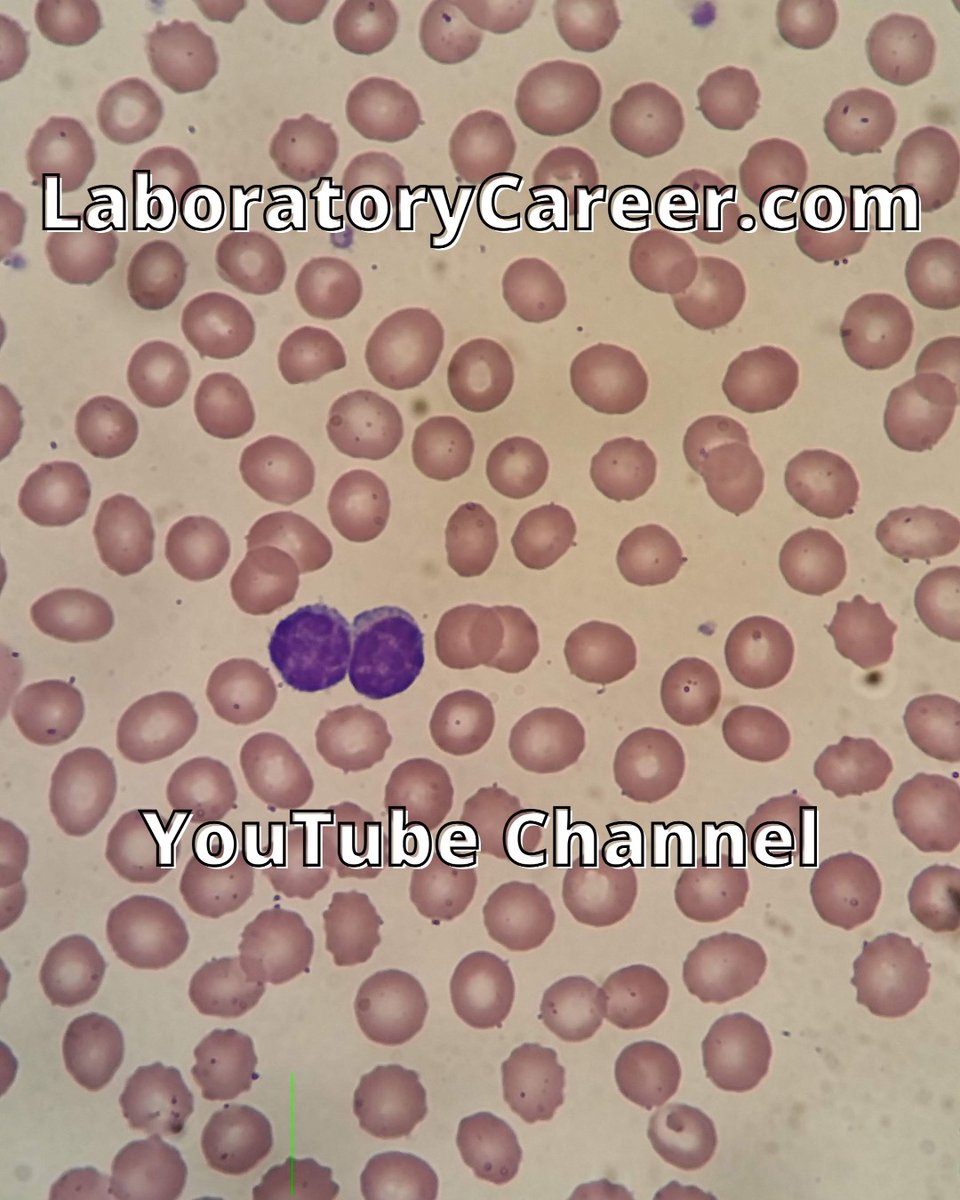
lab_career's tweet image. CHRONIC LYMPHOCYTIC LEUKEMIA (CLL) under the scope is a common finding for Medical Lab Scientists to discover. 
youtu.be/5QMZ9gqhAmo
#medicallabscientist #medicaltechnologist #clinicallabscience #cls #medicallabscience #medicaltechnology

#clinicallabscience 搜尋結果
Nothing beats the feel of the actual paper in your hands #neuroscience #brain #clinicallabscience #science #reviews. A great shoutout to Ghayda Mirzaa, because working with her it’s fun!

Medical laboratory sciences student Anthony Nguyen was awarded a Developing Professionals travel grant by the Ascending and Developing Professionals Forum of the American Society of Clinical Laboratory Science (ASCLS)! Congrats, Anthony! 🌟 #ClinicalLabScience

Med Lab Science Night 9/23/21 in Agenstein Hall. TMC, NKCH, St. Luke's, Advent, Mosaic, Qwest, and Nemaha will be here to visit with students about MLS careers. #Medlabscience #clinicallabscience #MWSUchemistry #griffonchemistry

What role do you play? youtube.com/shorts/TG-HGwi… #CLIA #LabDirector #ClinicalLabScience #LaboratoryManagement #MedicalLab #ToxicologyTuesdays #ContinuingEducation #Shorts #LabLife

youtube.com
YouTube
What is the role of a CLIA lab director in personnel management?
Little did I know 6 years ago when I was spending my days counting cells in clinical samples (urine with presence of RBCs shown in first pic) that I’d be looking at red blood cells like this now (second pic)😍🔬🩸#publicheath #clinicallabscience #hematology #phdlife #SEM #glowup


Attending ADLM 2024 in Chicago? Make plans to stop by booth #1017 to hear to about the future of CueSee. Be in the know and a part of lab innovation!! #clinicallabscience #POCtesting #qualitycontrols #labtest #bloodgas #coagulation #pointofcaretest

“Up to 10% of cancers are related to genetic mutation Whereas, 27% of cancer deaths are from tobacco and alcohol use.” #iamandiwill #laboratorycareer #clinicallabscience #medtech #healthcare

Patient Recognition Week- make a difference in patients’ lives by returning fast and accurate lab results as a Medical Lab Scientist! #patientcare #healthcareworkers #clinicallabscience #medicaltechnology

A photo ONLY A LAB TECH could admire! This beautiful UTI has numerous WBCs and rivers overflowing with bacteria. It is so cool to see these tiny organisms! #clinicallabscience #medicallabscience #laboratorycareer #sciencemajors

#Pharmaceutical Sciences 2019 | February 25-26, 2019 | Berlin, Germany Visit: lnnk.in/a5j #clinicaltrials #clinicallabscience #pharmacy #Pharmaceuticalmedicine @PolymerTech_Irl @polytechinc @PolymerUMass @PolymerTech @smartpolymer @smartmaterialco @PharmaEvent2019

CHRONIC LYMPHOCYTIC LEUKEMIA (CLL) under the scope is a common finding for Medical Lab Scientists to discover. youtu.be/5QMZ9gqhAmo #medicallabscientist #medicaltechnologist #clinicallabscience #cls #medicallabscience #medicaltechnology

AUDIT has had a wonderful time at the Lab Directors Summit in Ponte Vedra, FL. We have had the opportunity to meet and network with so many wonderful colleagues. Let us know in the comments what conferences we should attend next! #linearity #clinicallabscience #medicallaboratory

NEW YEAR...New You! Start YOUR lab career journey in 2022 laboratorycareer.com/mls #stemjobsindemand #clinicallabscience #bachelorsinscience #labjobs #laboratorycareer

MLS vs CLS vs MT what's the difference? laboratorycareer.com/mls-vs-cls/ Why are there so many titles for Lab Professionals... #clinicallabscience #medicallabscience #medtech #medicaltechnologist

What role do you play? youtube.com/shorts/TG-HGwi… #CLIA #LabDirector #ClinicalLabScience #LaboratoryManagement #MedicalLab #ToxicologyTuesdays #ContinuingEducation #Shorts #LabLife

youtube.com
YouTube
What is the role of a CLIA lab director in personnel management?
AUDIT has had a wonderful time at the Lab Directors Summit in Ponte Vedra, FL. We have had the opportunity to meet and network with so many wonderful colleagues. Let us know in the comments what conferences we should attend next! #linearity #clinicallabscience #medicallaboratory

New Product Alert! Linearity LQ Ammonia/Alcohol for Ortho Vitros, Order Number K830M-5, is now available! This product contains the following analytes: ammonia, alcohol. For more information and to order, visit our website auditmicro.com/linearity-lq-a… #clinicallabscience #medicallab

Medical laboratory sciences student Anthony Nguyen was awarded a Developing Professionals travel grant by the Ascending and Developing Professionals Forum of the American Society of Clinical Laboratory Science (ASCLS)! Congrats, Anthony! 🌟 #ClinicalLabScience

Check out what one of our mentees had to say! Apply to our Global Mentorship Program, especially if you're interested in mentoring individuals like Kaushal! medlabscholar.com/mentors/ #medlabscholar #medlabscience #clinicallabscience #mentorship #mentors
Attending ADLM 2024 in Chicago? Make plans to stop by booth #1017 to hear to about the future of CueSee. Be in the know and a part of lab innovation!! #clinicallabscience #POCtesting #qualitycontrols #labtest #bloodgas #coagulation #pointofcaretest

#PreLaw, #PoliticalScience, and #ClinicalLabScience are just a few of the many programs/activities featured in blogs on my website. Check them out at u3k4college.com Please retweet. #smallcolleges #collegesearch #colleges #collegecounseling #edchat #education #liberalarts
#PreLaw, #PoliticalScience, and #ClinicalLabScience are just a few of the many programs/activities featured in blogs on my website. Check them out at u3k4college.com Please retweet. #smallcolleges #collegesearch #colleges #collegecounseling #edchat #education #liberalarts
#PreLaw, #PoliticalScience, and #ClinicalLabScience are just a few of the many programs/activities featured in blogs on my website. Check them out at u3k4college.com Please retweet. #smallcolleges #collegesearch #colleges #collegecounseling #edchat #education #liberalarts
#PreLaw, #PoliticalScience, and #ClinicalLabScience are just a few of the many programs/activities featured in blogs on my website. Check them out at u3k4college.com Please retweet. #smallcolleges #collegesearch #colleges #collegecounseling #edchat #education #liberalarts
Core lab or KORRA lab?!? #ClinicalLabScience #CLS #Cytology #Pathology #CoreLab #TheLegendOfKorra
#PreLaw, #PoliticalScience, and #ClinicalLabScience are just a few of the many programs/activities featured in blogs on my website. Check them out at u3k4college.com Please retweet. #smallcolleges #collegesearch #colleges #collegecounseling #edchat #education #liberalarts
#PreLaw, #PoliticalScience, and #ClinicalLabScience are just a few of the many programs/activities featured in blogs on my website. Check them out at u3k4college.com Please retweet. #smallcolleges #collegesearch #colleges #collegecounseling #edchat #education #liberalarts
#PreLaw, #PoliticalScience, and #ClinicalLabScience are just a few of the many programs/activities featured in blogs on my website. Check them out at u3k4college.com Please retweet. #smallcolleges #collegesearch #colleges #collegecounseling #edchat #education #liberalarts
#PreLaw, #PoliticalScience, and #ClinicalLabScience are just a few of the many programs/activities featured in blogs on my website. Check them out at u3k4college.com Please retweet. #smallcolleges #collegesearch #colleges #collegecounseling #edchat #education #liberalarts
Medical laboratory sciences student Anthony Nguyen was awarded a Developing Professionals travel grant by the Ascending and Developing Professionals Forum of the American Society of Clinical Laboratory Science (ASCLS)! Congrats, Anthony! 🌟 #ClinicalLabScience

Attending ADLM 2024 in Chicago? Make plans to stop by booth #1017 to hear to about the future of CueSee. Be in the know and a part of lab innovation!! #clinicallabscience #POCtesting #qualitycontrols #labtest #bloodgas #coagulation #pointofcaretest

Nothing beats the feel of the actual paper in your hands #neuroscience #brain #clinicallabscience #science #reviews. A great shoutout to Ghayda Mirzaa, because working with her it’s fun!

Little did I know 6 years ago when I was spending my days counting cells in clinical samples (urine with presence of RBCs shown in first pic) that I’d be looking at red blood cells like this now (second pic)😍🔬🩸#publicheath #clinicallabscience #hematology #phdlife #SEM #glowup


“Up to 10% of cancers are related to genetic mutation Whereas, 27% of cancer deaths are from tobacco and alcohol use.” #iamandiwill #laboratorycareer #clinicallabscience #medtech #healthcare

#Pharmaceutical Sciences 2019 | February 25-26, 2019 | Berlin, Germany Visit: lnnk.in/a5j #clinicaltrials #clinicallabscience #pharmacy #Pharmaceuticalmedicine @PolymerTech_Irl @polytechinc @PolymerUMass @PolymerTech @smartpolymer @smartmaterialco @PharmaEvent2019

Patient Recognition Week- make a difference in patients’ lives by returning fast and accurate lab results as a Medical Lab Scientist! #patientcare #healthcareworkers #clinicallabscience #medicaltechnology

A photo ONLY A LAB TECH could admire! This beautiful UTI has numerous WBCs and rivers overflowing with bacteria. It is so cool to see these tiny organisms! #clinicallabscience #medicallabscience #laboratorycareer #sciencemajors

AUDIT has had a wonderful time at the Lab Directors Summit in Ponte Vedra, FL. We have had the opportunity to meet and network with so many wonderful colleagues. Let us know in the comments what conferences we should attend next! #linearity #clinicallabscience #medicallaboratory

NEW YEAR...New You! Start YOUR lab career journey in 2022 laboratorycareer.com/mls #stemjobsindemand #clinicallabscience #bachelorsinscience #labjobs #laboratorycareer

CHRONIC LYMPHOCYTIC LEUKEMIA (CLL) under the scope is a common finding for Medical Lab Scientists to discover. youtu.be/5QMZ9gqhAmo #medicallabscientist #medicaltechnologist #clinicallabscience #cls #medicallabscience #medicaltechnology
MLS vs CLS vs MT what's the difference? laboratorycareer.com/mls-vs-cls/ Why are there so many titles for Lab Professionals... #clinicallabscience #medicallabscience #medtech #medicaltechnologist

Lab Professionals have the best of both worlds- stability of working in healthcare without direct patient contact! laboratorycareer.com/mls #cls #clinicallabscience #biologymajor #labcareers

HOW DO YOU decide on the best CLS/MLS/MT Internship Program for you? Check out our list to get you started deciphering among the internships. laboratorycareer.com/cls-internship #medicallabscience #clinicallabscience #labcareer #medicaltechnology

Med Lab Science Night 9/23/21 in Agenstein Hall. TMC, NKCH, St. Luke's, Advent, Mosaic, Qwest, and Nemaha will be here to visit with students about MLS careers. #Medlabscience #clinicallabscience #MWSUchemistry #griffonchemistry

Something went wrong.
Something went wrong.
United States Trends
- 1. #StrangerThings5 59.4K posts
- 2. Thanksgiving 566K posts
- 3. Afghan 159K posts
- 4. #AEWDynamite 16.5K posts
- 5. National Guard 499K posts
- 6. #Survivor49 2,223 posts
- 7. Kevin Knight 1,944 posts
- 8. Rahmanullah Lakanwal 64.5K posts
- 9. holly 24.3K posts
- 10. dustin 84.1K posts
- 11. Cease 27.3K posts
- 12. Doris Burke N/A
- 13. Celtics 14K posts
- 14. Rizo 2,062 posts
- 15. robin 47.6K posts
- 16. Blood 253K posts
- 17. Savannah 5,127 posts
- 18. #TheChallenge41 N/A
- 19. Operation Allies Welcome 21.1K posts
- 20. #SistasOnBET N/A















